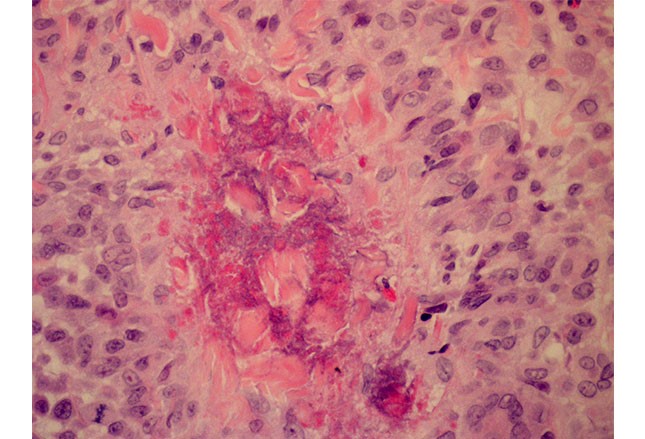
图文并茂:风湿性疾病的皮肤症状之银屑病、白

图文并茂:风湿性疾病的皮肤症状之银屑病、白
645x439 - 60KB - JPEG

类风湿性关节炎症状-乐哈健康网
500x350 - 16KB - JPEG

图文并茂:风湿性疾病的皮肤症状之银屑病、白
645x439 - 32KB - JPEG

血管炎有哪些症状?-健康提醒-保健资讯_保健商
400x300 - 30KB - JPEG

儿童类风湿会有什么症状表现_类风湿
540x335 - 26KB - JPEG

图文并茂:风湿性疾病的皮肤症状之银屑病、白
645x439 - 103KB - JPEG

雷诺氏症临床诊断标准是什么
292x229 - 11KB - JPEG

熟悉又陌生的风湿病
429x286 - 30KB - JPEG

图文并茂:风湿性疾病的皮肤症状之银屑病、白
645x439 - 37KB - JPEG
图文并茂:风湿性疾病的皮肤症状之银屑病、白
645x439 - 81KB - JPEG

图文并茂:风湿性疾病的皮肤症状之银屑病、白
645x439 - 55KB - JPEG

图文并茂:风湿性疾病的皮肤症状之银屑病、白
645x439 - 32KB - JPEG

图文并茂:风湿性疾病的皮肤症状之银屑病、白
645x439 - 145KB - JPEG

类风湿危害心脏 类风湿给心脏造成那些伤害
400x400 - 19KB - JPEG

怎样诊断原发性血管炎疾病
350x221 - 11KB - JPEG
概述类风湿性血管炎:表现为远端血管炎,皮肤溃疡,周围神经病变,心包炎,原因表现为远端血管炎,皮肤溃疡
而类风湿血管炎(rheumatoidvasculitis,RV)是RA常见严重并发症。但如果不治疗或治疗延迟,巩膜炎或可导致
健康咨询描述:我在前几年得了类(一)除暴发性类风湿血管炎外,一般都有类风湿性关节炎病史,血管炎多出现在
像这样的情况,推荐中医治疗.类风湿血管炎是类风湿关节炎的基本病变之一,血管炎可有如下表现:(1)皮肤溃疡
我老婆患有类风湿血管炎,小腿出现皮疹,关节疼,有时疼痛难忍下面让我来和大家分享下类风湿血管炎的症状。
类风湿血管炎的说法并不标准 国际上没有得到认可 类风湿血管炎可累及全身任何一个脏器,如皮肤、肌肉、眼、
春节前确诊为干燥综合征,浑身肌肉疼,关节疼,下肢发凉,有血管炎症状,经鞍山类风湿性血管炎有哪些症状
类风湿性血管炎有哪些症状,双小腿冰凉 无知觉发病时间:2009年2月化验检查结果:类风湿性血管炎